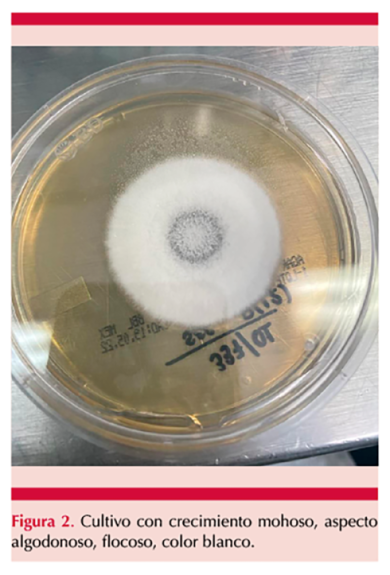

Dermatol Rev Mex. 2025; 69 (5): 735-738. https://doi.org/10.24245/dermatolrevmex.v69i5.10749
Irasema Romero González,1 Karen Dianeth Ríos Cisneros,2 José Luis Parra Herrera,3 Rogelio de Jesús Treviño Rangel,4 Efrén Robledo Leal,4 Vanessa del Carmen Escalona Morales,4 Karen Lorena López Aguado Amador5
1 Dermatóloga.
2 Residente del primer año de Dermatología.
3 Infectólogo.
Hospital General de Zona 33, Instituto Mexicano del Seguro Social, Monterrey, Nuevo León, México.
4 Departamento de Microbiología e Inmunología, Facultad de Ciencias Biológicas, UANL, Monterrey, Nuevo León, México.
5 Residente de tercer año de Dermatología, Clínica Hospital ISSSTE Constitución, Monterrey, Nuevo León, México.
ANTECEDENTES
La coccidioidomicosis, o fiebre del valle de San Joaquín, es una micosis sistémica causada por el hongo dimorfo Coccidioides immitis y Coccidioides posadasii.1 Se considera endémica en regiones áridas del sureste de Estados Unidos y norte de México.2 La principal forma de infección es la pulmonar, pero existen otras formas como la coccidioidomicosis cutánea primaria, con muy pocos casos reportados en todo el mundo.3,4
CASO CLÍNICO
Paciente femenina de 65 años, originaria de Durango y residente de Nuevo León, con antecedente de diabetes mellitus 2, obesidad, safenectomía en 2014 y gonartrosis de la rodilla izquierda tratada con inyección intraarticular con corticosteroides en múltiples ocasiones (la última en 2015). En 2016 viajó a Ciudad Juárez, Chihuahua, y ese mismo año manifestó un nódulo eritematoso con drenaje purulento en la cara anterolateral de la pierna izquierda que se acompañaba de dolor. Recibió múltiples esquemas de antibiótico (cefalotina, levofloxacina, metronidazol), sin mejoría. Cinco años después acudió al servicio de dermatología donde se observó una dermatosis localizada en el muslo y la pierna izquierda, con distribución lineal en la cara anterior, interna y el hueco poplíteo, constituida por nódulos y úlceras que fistulizaban y drenaban material purulento, con cicatriz retráctil. Figura 1

El cultivo para hongos mostró crecimiento de hongos filamentosos con colonias blancas, con crecimiento micelial algodonoso y flocoso (Figura 2). La tinción con azul de lactofenol reveló hifas que formaban artroconidios intercalados con células disyuntoras. La biopsia de piel evidenció un proceso inflamatorio crónico agudizado abscedado que penetraba la epidermis (Figura 3). En la tinción de Gomori-Grocott se observaron esférulas con endosporas en su interior (Figura 4), compatibles con Coccidioides spp. La secuenciación de ADN confirmó Coccidioides posadasii como agente etiológico, ITS: OP740677, D1/D2: OP740678. Se descartó enfermedad pulmonar, así como diseminación de ésta, y se estableció el diagnóstico de coccidioidomicosis cutánea primaria.

Se trató con fluconazol a dosis de 400 mg/día con alivio completo de las lesiones en seis meses; sin embargo, tras la suspensión del tratamiento, reaparecieron tres nódulos eritematosos en la pierna izquierda, dos de ellos ulcerados. Se indicó voriconazol 200 mg cada 12 horas durante un mes seguido de fluconazol 400 mg/día de forma indefinida. Actualmente, la paciente únicamente tiene cicatrices.
DISCUSIÓN
La coccidioidomicosis cutánea primaria, una forma rara de manifestación de esta enfermedad, es una micosis de implantación porque requiere un traumatismo que afecte la barrera cutánea para adquirir la infección.4 Su topografía más frecuente son las extremidades inferiores, seguidas de las superiores y la cara. En términos clínicos puede iniciar como una pápula o chancro nodular o verrugoso indoloro que ulcera y forma una placa con múltiples nódulos y pústulas con secreción serohemática que sigue un patrón de distribución linfática lineal e, incluso, puede asociarse con adenopatía regional.5,6
Para el diagnóstico de coccidioidomicosis debe considerarse la historia clínica, la identificación de factores de riesgo (modificables y no modificables), el examen físico y las pruebas diagnósticas; las más utilizadas son la microscopia directa, el cultivo micológico, la serología y la histopatología. El cultivo micológico permite el crecimiento del hongo en medios estándar, con una incubación de 2 a 7 días. Inicialmente, las colonias tienen una apariencia glabra que evoluciona a vellosas y posteriormente algodonosa, de color blanco-grisáceo, como se observó en la paciente del caso.
La microscopia directa con tinción de Gomori-Grocott, de ácido periódico de Schiff (PAS) o de hematoxilina-eosina, permite mejorar la visualización de las esférulas de doble pared retráctil, de 10 a 80 µm, con endosporas en su interior características de este hongo.7,8
Los principales factores de riesgo modificables incluyen exposición ocupacional y recreativa al aire libre, como el viaje realizado a zona endémica en Ciudad Juárez, Chihuahua. Los factores de riesgo no modificables son la edad avanzada e inmunosupresión, como en la paciente del caso por diabetes y obesidad.2
El tratamiento de coccidioidomicosis cutánea primaria se basa en antifúngicos sistémicos: fluconazol, itraconazol o voriconazol. En la actualidad los únicos fármacos aprobados por la FDA para el tratamiento de estos hongos son anfotericina B y ketoconazol, aunque su administración es limitada debido a efectos adversos significativos. El fluconazol es eficaz en la piel, el cerebro, los huesos y las articulaciones; se administra a dosis de 400 mg/día vía oral durante 6-12 meses, según la evolución clínica.5,8 La paciente del caso reaccionó favorablemente al tratamiento con fluconazol, pero su suspensión prematura provocó recurrencia de las lesiones, lo que resalta la importancia de la duración adecuada del tratamiento para prevenir recaídas.9
Conclusiones
Debido a que la coccidioidomicosis cutánea primaria es una manifestación rara y poco documentada, este caso resalta la importancia de su reconocimiento oportuno y tratamiento adecuado. La vigilancia a largo plazo y el apego al tratamiento antifúngico son decisivos para prevenir recaídas y complicaciones. Se requieren más estudios clínicos y epidemiológicos para establecer guías terapéuticas estandarizadas y definir la duración óptima del tratamiento antifúngico en esta forma clínica de la enfermedad.
REFERENCIAS
1. Crum NF. Coccidioidomycosis: A contemporary review. Infect Dis Ther 2022; 11 (2): 713. https://doi.org.10.1007/s40121-022-00569-4
2. Laniado-Laborín R, Arathoon EG, Canteros C, et al. Coccidioidomycosis in Latin America. Med Mycol 2019; 57 (Suppl 1): S46-55. https://doi.org.10.1093/mmy/myy037
3. Johnson RH, Sharma R, Kuran R, et al. Coccidioidomycosis: A review. J Invest Med 2021; 69 (2): 316-23. https://doi.org.10.1136/jim-2020-00165
4. Galindo-Talamantes FJ, Vázquez-González JG, Córdova-López J, et al. Coccidioidomicosis cutánea primaria y sus criterios para clasificación. Dermatol Rev Mex 2022; 66 (5): 593-7. https://doi.org.10.1016/j.dermac.2022.05.003
5. García-García SC, Salas-Alanis JC, Gómez-Flores M, et al. Coccidioidomycosis and the skin: a comprehensive review. An Bras Dermatol 2015; 90 (5): 610-21. https://doi.org.10.1590/0365-059620150053
6. Lee G, Scott GA, Munsiff SS, et al. Locally recurrent primary cutaneous coccidioidomycosis. JAAD Case Rep 2021; 16: 161. https://doi.org.10.1016/j.jdcr.2021.06.014
7. Williams SL, Chiller T. Update on the epidemiology, diagnosis, and treatment of coccidioidomycosis. J Fungi 2022; 8 (7): 666. https://doi.org.10.3390/jof807066
8. McHardy IH, Barker B, Thompson GR. Review of clinical and laboratory diagnostics for coccidioidomycosis. J Clin Microbiol 2023; 61 (5): e01581-22. https://doi.org.10.1128/JCM.01581-22
9. Reyna-Rodríguez IL, Ocampo-Candiani J, Chávez-Álvarez S. Primary cutaneous coccidioidomycosis: An update. Am J Clin Dermatol 2020; 21 (5): 681-96. https://doi.org.10.1007/s40257-020-00519-2
ORCID
https://orcid.org/0009-0004-5099-9606
https://orcid.org/0009-0003-2801-5888
https://orcid.org/0000-0002-1937-5721
https://orcid.org/0000-0002-4433-6556
https://orcid.org/0000-0002-1445-2839
https://orcid.org/0009-0004-4078-3342
Recibido: enero 2024
Aceptado: mayo 2025
Este artículo debe citarse como: Romero-González I, Ríos-Cisneros KD, Parra-Herrera JL, Treviño-Rangel RJ, Robledo-Leal E, Escalona-Morales VC, López-Aguado Amador KL. Úlceras crónicas por coccidioidomicosis cutánea primaria, diagnóstico inusual. Dermatol Rev Mex 2025; 69 (5): 735-738.

